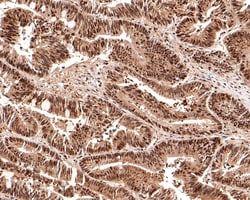
Invitrogen RSK2 Recombinant Rabbit Monoclonal Antibody (JE63-19) 100 &mu;L;

missing translation for 'onlineSavingsMsg'
Learn More
Learn More
Invitrogen™ RSK2 Recombinant Rabbit Monoclonal Antibody (JE63-19)


Rabbit Recombinant Monoclonal Antibody
Brand: Invitrogen™ MA544775
This item is not returnable.
View return policy
Description
RSK2 Recombinant Monoclonal Antibody for Western Blot, IHC (P), Flow
RPS6KA3 (RSK2) is a serine/threonine kinase that modulates many cellular processes including transcription, adhesion, growth, survival, and proliferation. RPS6KA3 contains 2 non-identical kinase catalytic domains and phosphorylates various substrates, including members of the mitogen-activated kinase (MAPK) signalling pathway. The activity of this protein has been implicated in controlling cell growth and differentiation. Mutations in the gene have been associated with Coffin-Lowry syndrome (CLS).
Specifications
| RSK2 | |
| Recombinant Monoclonal | |
| 1 mg/mL | |
| TBS with 0.05% BSA, 40% glycerol and 0.05% sodium azide; pH 7.4 | |
| P18654, P51812 | |
| RPS6KA3 | |
| Synthetic peptide within human RSK2 aa 661-710/740. | |
| 100 μL | |
| Primary | |
| Human, Mouse, Rat | |
| Antibody | |
| IgG |
| Flow Cytometry, Immunohistochemistry (Paraffin), Western Blot | |
| JE63-19 | |
| Unconjugated | |
| RPS6KA3 | |
| 90 kDa ribosomal protein S6 kinase 3; C130006E23; CLS; HU-3; Insulin-stimulated protein kinase 1; ISPK1; ISPK-1; MAP kinase-activated protein kinase 1b; MAPK-activated protein kinase 1b; MAPKAP kinase 1b; MAPKAPK1B; MAPKAPK-1b; MPK-9; MRX19; p90-RSK 3; p90-RSK2; p90RSK3; pp90RSK2; RGD1563860; ribosomal protein S6 kinase 2; ribosomal protein S6 kinase A3; ribosomal protein S6 kinase alpha-3; ribosomal protein S6 kinase polypeptide 3; ribosomal protein S6 kinase, 90kDa, polypeptide 3; ribosomal S6 kinase 2; Rps6ka3; Rps6ka-rs1; RSK; Rsk2; RSK-2; S6K-alpha3; S6K-alpha-3 | |
| Rabbit | |
| Protein A | |
| RUO | |
| 110651, 501560, 6197 | |
| Store at 4°C short term. For long term storage, store at -20°C, avoiding freeze/thaw cycles. | |
| Liquid |
Product Content Correction
Your input is important to us. Please complete this form to provide feedback related to the content on this product.
Product Title
Spot an opportunity for improvement?Share a Content Correction